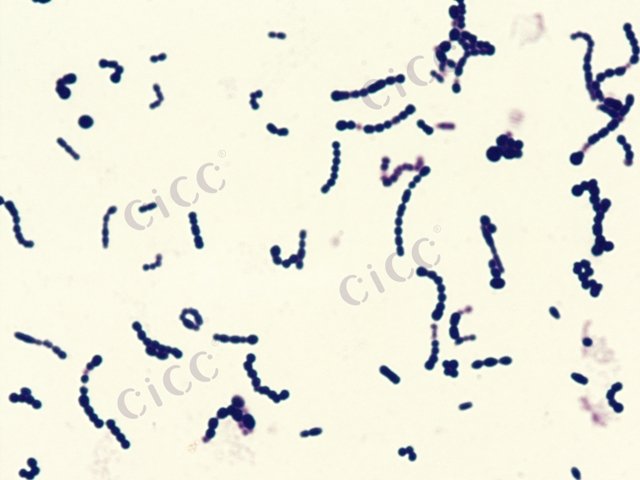
酿脓链球菌 Streptococcus pyogenes CICC 10356 Streptococcus pyogenes

酿脓链球菌 Streptococcus pyogenes CICC 10356 Streptococcus pyogenes
-
酿脓链球菌 Streptococcus pyogenes CICC 10373 Streptococcus pyogenes
CICC 10373 | 见证书
-
酿脓链球菌 Streptococcus pyogenes CICC 10464 Streptococcus pyogenes
CICC 10464 | 见证书
-
酿脓链球菌 Streptococcus pyogenes
BNCC353771 | 冻干粉;菌液;平板
-
酿脓链球菌 Streptococcus pyogenes
BNCC365050 | 冻干粉;斜面;菌液;平板
-
酿脓链球菌 Streptococcus pyogenes
BNCC139857 | 冻干粉;菌液;平板
-
酿脓链球菌 Streptococcus pyogenes ATCC 19615 Culti-Loop Streptococcus pyogenes ATCC® 19615™
R4607000 | 5支/包
-
化脓性链球菌 Streptococcus pyogenes
BNCC370002 | 冻干粉;平板

说明书下载: 菌种说明书 打管说明书
您正在浏览的产品:酿脓链球菌 Streptococcus pyogenes CICC 10356
手机版:酿脓链球菌 Streptococcus pyogenes CICC 10356
本公司销售的所有产品仅供实验科研使用,不用于人体及临床诊断。
本标准适用于食品中β型溶血性链球菌(包括酿脓链球菌)的定性检测,覆盖食品生产、加工及流通环节的微生物安全控制[7][9]。
采用选择性培养基(血琼脂平板)分离结合生化鉴定(杆菌肽敏感性试验、PYR试验)确认目标菌株。
最低检出限为1 CFU/25g样品;定量检测需通过梯度稀释法实现。
需同步进行阳性对照(ATCC 19615标准菌株)及阴性对照试验,培养基每批次需验证溶血特性。
1. 样品前处理(均质与增菌)
2. 选择性培养(35℃±1℃, 18-24h)
3. 典型菌落分离与纯化
4. 生化鉴定与血清学分型
实验人员需具备BSL-2级生物安全防护资质,疑似阳性样品需经省级以上CDC复核确认。
针对食品工业用酶制剂中酿脓链球菌等微生物污染的风险评估,规定抗菌活性检测阈值[7]。
采用琼脂扩散法测定抑菌圈直径,结合标准菌株(CMCC 32213)进行活性比对。
可检测≥5mm的抑菌圈,定量活性单位为IU/mg(国际单位/毫克)。
每批次实验需包含空白对照(无菌生理盐水)及标准品对照(已知活性酶制剂)。
1. 菌悬液制备(0.5麦氏浊度)
2. 双层琼脂倾注法
3. 恒温培养(35℃, 24h)
4. 抑菌圈测量与结果判定
需注意酶制剂的pH稳定性,实验环境温度波动需控制在±1℃范围内。
规范出口食品中酿脓链球菌的分子分型流程,适用于溯源分析与疫情暴发调查[3][6]。
基于多位点序列分型(MLST),测定7个管家基因(如gki、gtr等)的核苷酸序列。
DNA提取浓度需≥10ng/μL,PCR扩增效率要求≥90%。
需包含国际标准菌株(如ATCC 12344)作为分型参照,每批次实验设置阴性对照。
1. 细菌基因组DNA提取
2. 靶基因PCR扩增与纯化
3. 双向测序与序列拼接
4. 等位基因谱比对分析
实验室需通过CNAS分子生物学检测能力认证,原始数据需保存10年以上。
以上信息仅供参考,请以相应标准的原文为准!